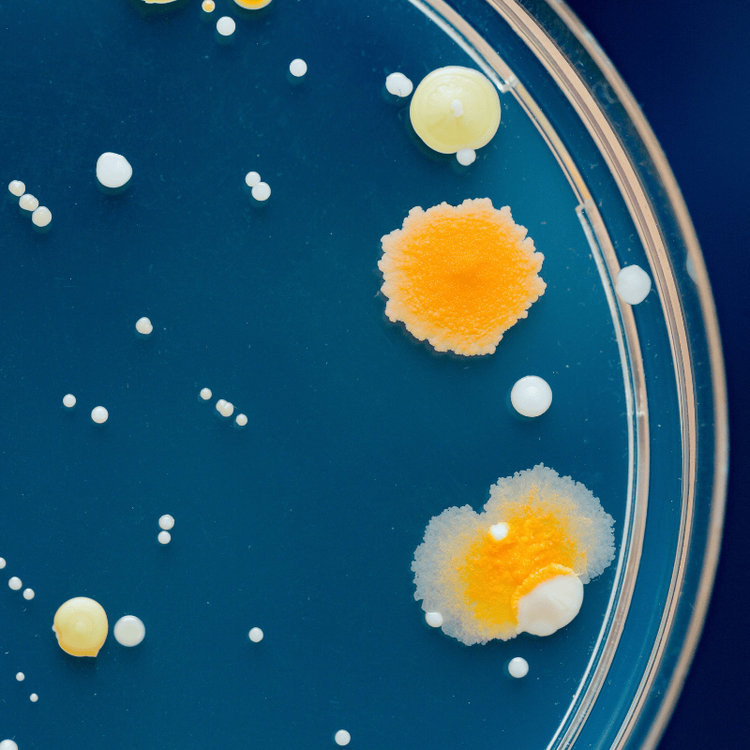

Graduate Programs
Molecular and Cellular Biology Programs

MSc in Molecular and Cellular Biology
MSc MCB students graduate with a high level of knowledge and expertise in contemporary molecular and cellular biology, including experimental techniques, library research, writing and communication skills.

PhD in Molecular and Cellular Biology
Students in the PhD in Molecular and Cellular Biology develop into independent and creative scientists, ready to take on roles as scholars in academia or as leaders in industry or government.
Master of Applied Molecular and Health Sciences
A first-of-its-kind in Canada, the Master of Applied Molecular and Health Sciences (MAMHS) is a one-year, course-based graduate program that blends advanced molecular biology with emerging fields, such as AI-driven drug discovery, immunology, and stem cell research models.

Master of Medical Foundations
The Master of Medical Foundations (MMF) is an 11-month, course-based graduate program providing both theoretical and practical training in human anatomy, multisystem physiology, and disease and immunology, with a focus on the role of lifestyle medicine and social dimensions of health and wellbeing.
Collaborative Specializations
A collaborative specialization is an intra-university graduate field of study that provides an additional multidisciplinary experience for students enrolled in and completing the degree requirements for their MSc or PhD in Molecular and Cellular Biology degree.

Neuroscience

Toxicology

One Health
Interdepartmental Programs


Bioinformatics
(MSc, PhD and course-based Master of Bioinformatics)

